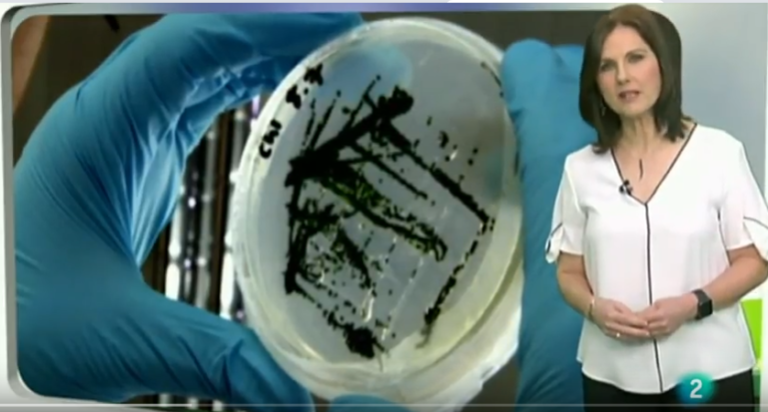

AlgaEnergy e il potenziale delle microalghe, protagonisti in Telemadrid
Un team di "Informativos" ha visitato le strutture della Piattaforma Tecnologica per la Sperimentazione con le Microalghe (PTEM) e ha dedicato uno spazio eccezionale ad AlgaEnergy.